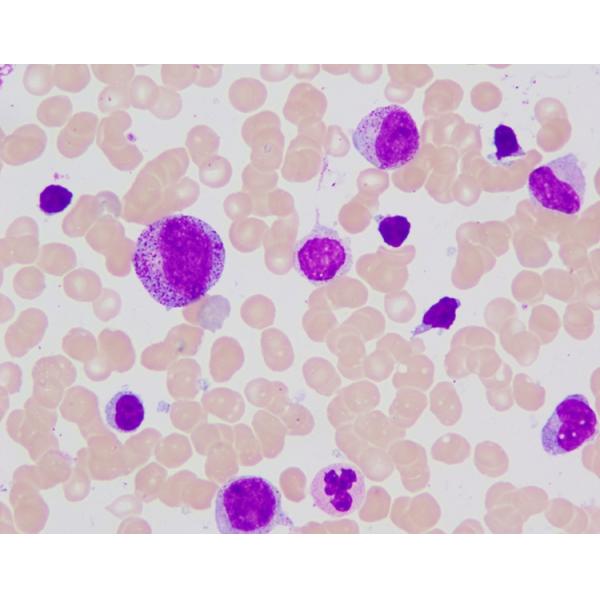

| Sign In | Join Free | My wneducation.com |
|
- Home
- Products
- About Us
- Quality Control
- Contact Us
- Get Quotations
| Sign In | Join Free | My wneducation.com |
|
Brand Name : Baso
Certification : IVDR Class A; ISO 13485:2016
Applicable Departments : Hospital,Clinic,Research Institution
Method : Wright-Giemsa
MOQ : 1 Box
Price : Negotiated
Payment Terms : T/T
Packaging Details : Paper box
Delivery Time : To be confirmed
Supply Ability : To be confirmed
Wright-Giemsa Stain (For Auto Stainer) Baso Clear Colourful Stains
Testing Principle
This product is developed based on an improved version of the Romanowsky Stain technique. The cell staining process involves the penetration and retention of dyes within the stained material, encompassing both physical adsorption and chemical affinity. Due to the differing chemical properties of various cells and their components, their affinity towards the acidic dye (eosin) and basic dye (methylene blue) in the Wright-Giemsa staining solution varies. Consequently, after staining, different types of cells exhibit distinct colorations, thereby facilitating the identification of their morphological characteristics.
Stain Results
Red blood cells appear pink, while the granules in the cytoplasm of white blood cells are clearly visible, displaying the unique colors characteristic of each cell type. The cell nuclei are stained purple-red, with clearly visible chromatin structures.
Packaging Specification
|
Product Name
| Ref # | Specification |
| Wright-Giemsa Stain (For Auto Stainer) | BA4368 | 4X1000ML |
|
|
Hospital / Research Institution Wright Giemsa Stain Solution For Auto Stainer Images |